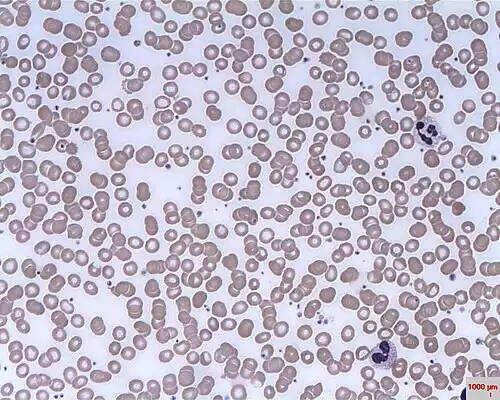

فرهنگستان زبان و ادب
[پزشکی] ← خون پزشکی
[پزشکی] ← خون پزشکی
خون شناسی یا هماتولوژی ( به انگلیسی: Hematology ) به مطالعه یاخته های خونی، انعقاد خون و فرایند خون سازی و درمان و پیشگیری از بیماری های مرتبط با خون می پردازد. این علم مقدار و ساختمان و عمل سلول های خونی، پیش سازهای سلول های خونی در مغز استخوان، ساختارهای شیمیایی پلاسما و عمل پلاکت ها و پروتئین هایی که در سیستم انعقادی دخالت دارند را بررسی می کند. از جمله بیماری های هموفیلی، آنمی، لخته شدن خون، سایر اختلالات خون ریزی و سرطان های خون مانند لنفوم در این دسته قرار دارند. آنالیز آزمایشگاهی خون اغلب توسط پزشک یا کارشناس ارشد آزمایشگاه انجام می شود.
هماتولوژی در اصل مطالعه اختلالات خونی و خون است. هماتولوژیست ها و هماتوپاتولوژیست ها ارائه دهندگان مراقبت های بهداشتی بسیار آموزش دیده ای هستند که در بیماری های خون و اجزای خون تخصص دارند. در حالی که بخش عمده ای از زمان متخصص هماتولوژی صرف ارائه مراقبت های بالینی مستقیم به بیماران می شود، کار تشخیصی در آزمایشگاه نیز بخش مهمی از کار آن ها است.
هماتولوژی با رشته های مختلف پزشکی و علوم پایه از جمله ایمنی شناسی، ژنتیک مولکولی، ژنتیک پزشکی و انسانی ارتباط نزدیک دارد.
این رشته در ایران به چندین روش قابل فراگیری است: یک: در مقطع کارشناسی ارشد و دکترای هماتولوژی، با تاکید بر فرایندهای ارزیابی و تشخیصی در آزمایشگاه و تحقیقات پیرامون آن. دو: در مقطع فوق تخصص هماتولوژی و آنکولوژی ( که پس از کسب تخصص داخلی است ) با تاکید بر تشخیص و درمان بالینی بیماران.
همچنین در طب سنتی و پزشکی جایگزین ( alternative medicine ) نظریه هایی درباره ی تاثیر گروه خونی بر مزاج فرد و همچنین امکان تدوین برنامه ی غذایی بر مبنای گروه خونی فرد وجود دارد که البته نیاز به بررسی بیشتر جهت تایید یا رد دارد.
آنالایزرهای هماتولوژی برای انجام شمارش کامل خون ( CBC )، که معمولاً اولین آزمایشی است که توسط پزشکان برای تعیین وضعیت سلامت عمومی بیمار درخواست می شود، استفاده می شود. شمارش کامل خون شامل گلبول های قرمز ( RBC )، گلبول های سفید ( WBC )، هموگلوبین و تعداد پلاکت ها و همچنین سطح هماتوکریت است. تجزیه و تحلیل های دیگر عبارتند از:
• عرض توزیع RBC
• میانگین حجم جسمی
• میانگین هموگلوبین سلولی
• میانگین غلظت هموگلوبین سلولی
• تعداد دیفرانسیل WBC در درصد و قدر مطلق
• عرض توزیع پلاکت
• میانگین حجم پلاکت
• نسبت سلول های پلاکتی بزرگ
• معیارهای پلاکتی

جملات نمونه از منابع مختلف جمع آوری شده است، اگر صحیح نیست یا توهین آمیز است، لطفا گزارش دهید.
💡 ایمونوهماتولوژی که معمولاً به عنوان بانک خون شناخته میشود یکی از شاخههای خون شناسی است که به مطالعهٔ واکنشهای آنتی ژن - آنتی بادی برای تشخیص بیماریهای خونی میپردازد. از جمله وظایف یک ایمونوهماتولوژیست میتوان به تعیین گروه خونی، آزمایش کراس مج، و تعیین نوع پادتن اشاره کرد.
💡 گرچه که دستگاه قلبی-عروقی به طور لاینفکی به خون ارتباط دارد، کاردیولوژی نسبتاً دغدغه دانش خون شناسی و بیماری های مربوط به آن را ندارد. مشخصاً استثنائاتی نیز از خون شناسی وجود دارد که بر روی عملکرد قلب اثرگذار است، همچون آزمایشهای خون (اغتشاشات الکترولیتی، تروپونینها)، کاهش ظرفیت انتقال اکسیژن (کمخونی، شوک کمشدن حجم خون) و اختلالات انعقاد خون.